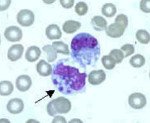

Другие названия и синонимы
Monocytic ehrlichiosis.
МКБ-10 коды
|
|
Описание
Моноцитарный эрлихиоз. Это инфекционное заболевание, передающееся клещами. Основными симптомами являются миалгия, сыпь, лихорадка. Реже встречаются тошнота, боли в животе, признаки повреждения дыхательных и мочевыводящих путей, а также центральной нервной системы: светобоязнь, рвота в верхней части головной боли, нарушение сознания, ригидность затылочных мышц, парез, паралич. Диагноз - обнаружение возбудителей с помощью микроскопии мазков крови методом ПЦР. Лечение проводится симптоматическими, патогенными и этиотропными средствами.

Дополнительные факты
Моноцитарный эрлихиоз человека является трансмиссивным заболеванием. Гематолог Maeda впервые описал нозологию в 1986 году (США), erlichia - 1935. Болезнь распространяется в Россию, Испанию, Мали, Португалию, Италию, Бельгию, США, Данию и Норвегию. Сезонность заболевания связана с переносчиками (поздняя весна - начало зимы) с пиками в мае-июне и октябре-декабре. Среди больных преобладают дети и мужчины, в основном жители сельской местности. Возраст инфицированных пациентов часто составляет 40-50 лет.
Причины
Возбудителем инфекции является внутриклеточная бактерия Ehrlichia, виды E. muris, E. chaffeensis. Водохранилищами и источниками моноцитарного эрлихиоза в дикой природе являются олени, реже лошади, собаки, козы, хомяки, койоты, мыши. Носителями являются клещи, чаще всего A. americanum, D. variabilis, I. pacificus, I. persulcatus. Считается, что эрлихия поражает до 50% популяции иксодовых клещей. Во время всасывания бактерии попадают в кровь человека со слюной.
Ключевые факторы риска:
• иммунодефициты любой этиологии.
• возраст старше 50 лет.
• размещение в районах с повышенной влажностью, смешанные леса.
• низкий доход, при котором люди вынуждены жить в неблагоприятных социально-гигиенических условиях, работать в местах обитания клещей. Бедность может быть косвенным фактором иммунодефицита, снижения грамотности, осведомленности о клещевых заболеваниях и методах их профилактики.
Ключевые факторы риска:
• иммунодефициты любой этиологии.
• возраст старше 50 лет.
• размещение в районах с повышенной влажностью, смешанные леса.
• низкий доход, при котором люди вынуждены жить в неблагоприятных социально-гигиенических условиях, работать в местах обитания клещей. Бедность может быть косвенным фактором иммунодефицита, снижения грамотности, осведомленности о клещевых заболеваниях и методах их профилактики.
Патогенез
Когда клещ высасывается, патоген вместе со слюной попадает в толщину кожи. Лимфогенный путь эрлихии проникает в кровоток, размножение происходит внутри эндотелиоцитов и моноцитов. После проникновения в клетку лейкоцитов начинается быстрое бинарное деление бактерии, образуется начальное тело, которое превращается в скопление элементарных тел внутри клетки (морула).
После разрушения клеток микроорганизмы попадают в кровоток, где они могут инфицировать другие клетки, часто белые клетки крови. Эрлихия поражает различные органы (кожу, печень, центральную нервную систему, костный мозг), где обнаруживаются инфекционные гранулемы. Возможность длительной персистенции бактерий в клетках организма человека и хронического течения моноцитарного эрлихиоза не исключена.
После разрушения клеток микроорганизмы попадают в кровоток, где они могут инфицировать другие клетки, часто белые клетки крови. Эрлихия поражает различные органы (кожу, печень, центральную нервную систему, костный мозг), где обнаруживаются инфекционные гранулемы. Возможность длительной персистенции бактерий в клетках организма человека и хронического течения моноцитарного эрлихиоза не исключена.
Клиническая картина
Инкубационный период составляет около 14 дней, реже 1-30 дней. Заболевание начинается с острых симптомов общей интоксикации: слабость, усталость, снижение работоспособности и головные боли. Состояние сопровождается лихорадкой выше 38 ° С, ознобом, продолжительность лихорадки может составлять до полутора недель. 2/3 пациентов с эрлихиозом имеют боль в горле, сухой кашель, заложенность носа.
Другие признаки инфекции включают увеличение поднижнечелюстных лимфатических узлов, боли в мышцах и суставах и покраснение конъюнктивы глаз и горла. Реже возникают эпизоды повышенного артериального давления, неравномерных узловых высыпаний на коже бедер, ног и тела, которые проходят без шелушения и не требуют лечения. У 10% пациентов развиваются симптомы менингита: светобоязнь, галлюцинации, трудности в контакте, рвота на уровне головы, снижение силы конечностей.
Ассоциированные симптомы: Боль в суставах. Высокая температура тела. Глубокий сухой кашель. Головная боль. Заложенность носа. Лейкопения. Озноб. Першение в горле. Общая слабость. Судороги в ногах. Увеличение СОЭ. Увеличение подчелюстных лимфоузлов.
Другие признаки инфекции включают увеличение поднижнечелюстных лимфатических узлов, боли в мышцах и суставах и покраснение конъюнктивы глаз и горла. Реже возникают эпизоды повышенного артериального давления, неравномерных узловых высыпаний на коже бедер, ног и тела, которые проходят без шелушения и не требуют лечения. У 10% пациентов развиваются симптомы менингита: светобоязнь, галлюцинации, трудности в контакте, рвота на уровне головы, снижение силы конечностей.
Ассоциированные симптомы: Боль в суставах. Высокая температура тела. Глубокий сухой кашель. Головная боль. Заложенность носа. Лейкопения. Озноб. Першение в горле. Общая слабость. Судороги в ногах. Увеличение СОЭ. Увеличение подчелюстных лимфоузлов.
Возможные осложнения
Наиболее серьезными осложнениями патологии являются респираторные симптомы (респираторный дистресс-синдром взрослых) и почечная недостаточность, миокардит, гипотензия, коагулопатия, геморрагические проявления. Токсический шок регистрируется у 2-5% больных. Неврологические симптомы возникают в 20% случаев моноцитарного эрлихиоза, включая изменение психического статуса, атаксию, сильную головную боль, слабость и судороги.
Диагностика
Диагноз и лечение подтверждены специалистом по инфекционным заболеваниям. Иногда требуется консультация невролога, в зависимости от показания привлекаются другие специалисты. В ходе обследования врач тщательно собирает эпидемиологический анамнез: факт и продолжительность отсасывания клеща, наличие химиопрофилактики. Поддерживающие клинические, лабораторные и инструментальные симптомы моноцитарного эрлихиоза:
• Физические данные. При объективном осмотре можно выявить макулопапулезную сыпь на туловище, бедрах и ногах, гиперемию лица, конъюнктиву, регионарные расширения лимфатических узлов, покраснение глотки, умеренную гепатомегалию и редко спленомегалию. При аускультации легких обнаруживаются отдельные сухие породы, в сердцах - относительная брадикардия, ослабление шумов в сердце. Повышение артериального давления не отмечено. Обязательно проверьте менингеальные симптомы.
• Лабораторные исследования. В общем анализе крови - лейкопения, лимфопения, моноцитопения, тромбоцитопения, ускоренное СОЭ, реже анемия. Активность АЛТ, АСТ, щелочной фосфатазы, ЛДГ при биохимическом скрининге значительно возрастает. При общем клиническом анализе мочи можно диагностировать протеинурию, эритроцитурию. Для ликворограммы характерен лимфоцитарный плеоцитоз, увеличение количества белка.
• Идентификация инфекционных агентов. Микроскопия тонкого окрашенного мазка крови или спинномозговой жидкости в цитоплазме нейтрофилов и моноцитов выявляет морулы (вакуоли), содержащие скопления эрлихий. Метод ПЦР используется до назначения антибиотиков. Серологические исследования (ИФА, РНИФ, иммуноблоттинг) имеют диагностическую значимость со второй недели заболевания. Дорогостоящим и длительным методом является выделение возбудителя эрлихиоза в клеточной культуре гистиоцитом собак.
• Инструментальные методы. Рентгенография грудной клетки визуализирует легочные инфильтраты у 50% пациентов. Когда появляются неврологические симптомы, рекомендуется КТ головного мозга. УЗИ брюшной полости, почек и лимфатических узлов выявляет увеличение печени и селезенки, а также регионарную лимфаденопатию для исключения воспалительных урологических симптомов. На ЭКГ у одной трети пациентов наблюдаются нарушения проводимости, диффузные изменения миокарда левого желудочка.
Дифференциальная диагностика проводится при пироплазмозе, характеризующемся анемией и спленомегалией, гранулоцитарным анаплазмозом человека, клинические симптомы которого практически неотличимы от моноцитарного эрлихиоза (требуется лабораторная проверка). болезнь Лайма передается клещами присутствии эритема, неисправности в системе опорно-двигательного аппарата, сердца и центральной нервной системы; Лихорадка Сеннецу вызывает патологию лимфатических узлов, селезенки.
• Физические данные. При объективном осмотре можно выявить макулопапулезную сыпь на туловище, бедрах и ногах, гиперемию лица, конъюнктиву, регионарные расширения лимфатических узлов, покраснение глотки, умеренную гепатомегалию и редко спленомегалию. При аускультации легких обнаруживаются отдельные сухие породы, в сердцах - относительная брадикардия, ослабление шумов в сердце. Повышение артериального давления не отмечено. Обязательно проверьте менингеальные симптомы.
• Лабораторные исследования. В общем анализе крови - лейкопения, лимфопения, моноцитопения, тромбоцитопения, ускоренное СОЭ, реже анемия. Активность АЛТ, АСТ, щелочной фосфатазы, ЛДГ при биохимическом скрининге значительно возрастает. При общем клиническом анализе мочи можно диагностировать протеинурию, эритроцитурию. Для ликворограммы характерен лимфоцитарный плеоцитоз, увеличение количества белка.
• Идентификация инфекционных агентов. Микроскопия тонкого окрашенного мазка крови или спинномозговой жидкости в цитоплазме нейтрофилов и моноцитов выявляет морулы (вакуоли), содержащие скопления эрлихий. Метод ПЦР используется до назначения антибиотиков. Серологические исследования (ИФА, РНИФ, иммуноблоттинг) имеют диагностическую значимость со второй недели заболевания. Дорогостоящим и длительным методом является выделение возбудителя эрлихиоза в клеточной культуре гистиоцитом собак.
• Инструментальные методы. Рентгенография грудной клетки визуализирует легочные инфильтраты у 50% пациентов. Когда появляются неврологические симптомы, рекомендуется КТ головного мозга. УЗИ брюшной полости, почек и лимфатических узлов выявляет увеличение печени и селезенки, а также регионарную лимфаденопатию для исключения воспалительных урологических симптомов. На ЭКГ у одной трети пациентов наблюдаются нарушения проводимости, диффузные изменения миокарда левого желудочка.
Дифференциальная диагностика проводится при пироплазмозе, характеризующемся анемией и спленомегалией, гранулоцитарным анаплазмозом человека, клинические симптомы которого практически неотличимы от моноцитарного эрлихиоза (требуется лабораторная проверка). болезнь Лайма передается клещами присутствии эритема, неисправности в системе опорно-двигательного аппарата, сердца и центральной нервной системы; Лихорадка Сеннецу вызывает патологию лимфатических узлов, селезенки.
|
|
Лечение
Стандарты медицинской помощи для пациентов с симптомами эрлихиоза не разработаны. Рекомендуется начинать лечение не позднее 5-го дня болезни и продолжать не менее 7-10 дней, несмотря на то, что самочувствие пациента улучшается в течение 24-48 часов после начала коррекции препарата. Терапия моноцитарным эрлихиозом обычно проводится с применением следующих препаратов:
Наиболее эффективными лекарственными средствами являются тетрациклические антибиотики (доксициклин, тетрациклин), рифампицин и хлорамфеникол. Применение сульфонамидов, согласно некоторым исследованиям, может привести к миокардиту, поэтому его не рекомендуется. Erlichia нечувствителен к антибактериальным препаратам серии пенициллина, цефалоспорину.
Проводится детоксикация путем внутривенных вливаний глюкозно-солевых, сукцинатсодержащих растворов, хлорозола, жаропонижающих (кроме аспирина), обезболивающих. При неврологических проявлениях назначаются глюкокортикостероиды, противосудорожные препараты, диуретики. При миокардите показаны НПВП, препараты калия, АТФ, инозин, антигистаминные препараты.
К ним относятся лекарственные средства, которые снимают симптомы, возникающие во время заболевания или лечения: витамины, местные противовоспалительные препараты для ирригации слизистых оболочек рта и носоглотки, противокашлевые, противодиарейные, спазмолитические, сорбенты, ферменты, психотропные, гипотензивные, антиаритмические, фармацевтические препараты. Может быть использована искусственная вентиляция легких, кислородотерапия.
Особый подход требуется для пациентов, страдающих моноцитарным эрлихиозом вследствие иммунодефицита, особенно ВИЧ-инфекции. Описанные единичные случаи приводят к летальному исходу, чаще всего причиной смерти являются геморрагические проявления, панцитопения, острая почечная и полиорганная недостаточность. Важно, чтобы пациенты своевременно получали этиотропные препараты (доксициклин) в адекватных дозировках.
Совместное использование доксициклина и эфирного масла A. conyzoides выявило потенцирующее влияние последнего на антибиотическую активность. Присутствие эфирных масел также мешает восстановительному механизму, необходимому для деления клеток микроорганизмов, так как эти масла действуют на бактериальные мембраны, способствуя их разрыву. Антиоксидантная и антипротозойная активность растения подтверждена.
Синдром активации макрофагов является дисфункциональным и потенциально фатальным гиперактивным ответом иммунной системы, который приводит к полиорганной недостаточности; Спусковым механизмом заболевания часто является моноцитарный эрлихиоз. Положительная динамика в этом синдроме была выявлена при лечении пациентов с экспериментальной комбинацией глюкокортикостероидов, доксициклина и анакинры.
Рекомендуется постельный режим до 3-5 дней при постоянной нормальной температуре тела. Лечение больных миокардитом проводится в строго горизонтальном положении. В связи с повреждением тканей печени назначается щадящая диета: исключаются маринады, жирные, жареные, кондитерские изделия, приправы, кофе, алкоголь. Питьевой режим должен быть увеличен из-за кипяченой воды и оральных растворов детоксикации.
Наиболее эффективными лекарственными средствами являются тетрациклические антибиотики (доксициклин, тетрациклин), рифампицин и хлорамфеникол. Применение сульфонамидов, согласно некоторым исследованиям, может привести к миокардиту, поэтому его не рекомендуется. Erlichia нечувствителен к антибактериальным препаратам серии пенициллина, цефалоспорину.
Проводится детоксикация путем внутривенных вливаний глюкозно-солевых, сукцинатсодержащих растворов, хлорозола, жаропонижающих (кроме аспирина), обезболивающих. При неврологических проявлениях назначаются глюкокортикостероиды, противосудорожные препараты, диуретики. При миокардите показаны НПВП, препараты калия, АТФ, инозин, антигистаминные препараты.
К ним относятся лекарственные средства, которые снимают симптомы, возникающие во время заболевания или лечения: витамины, местные противовоспалительные препараты для ирригации слизистых оболочек рта и носоглотки, противокашлевые, противодиарейные, спазмолитические, сорбенты, ферменты, психотропные, гипотензивные, антиаритмические, фармацевтические препараты. Может быть использована искусственная вентиляция легких, кислородотерапия.
Особый подход требуется для пациентов, страдающих моноцитарным эрлихиозом вследствие иммунодефицита, особенно ВИЧ-инфекции. Описанные единичные случаи приводят к летальному исходу, чаще всего причиной смерти являются геморрагические проявления, панцитопения, острая почечная и полиорганная недостаточность. Важно, чтобы пациенты своевременно получали этиотропные препараты (доксициклин) в адекватных дозировках.
Совместное использование доксициклина и эфирного масла A. conyzoides выявило потенцирующее влияние последнего на антибиотическую активность. Присутствие эфирных масел также мешает восстановительному механизму, необходимому для деления клеток микроорганизмов, так как эти масла действуют на бактериальные мембраны, способствуя их разрыву. Антиоксидантная и антипротозойная активность растения подтверждена.
Синдром активации макрофагов является дисфункциональным и потенциально фатальным гиперактивным ответом иммунной системы, который приводит к полиорганной недостаточности; Спусковым механизмом заболевания часто является моноцитарный эрлихиоз. Положительная динамика в этом синдроме была выявлена при лечении пациентов с экспериментальной комбинацией глюкокортикостероидов, доксициклина и анакинры.
Лечение моноцитарного эрлихиоза.
Амбулаторное лечение разрешено при нозологии легкой и средней степени тяжести. Госпитализация рекомендуется детям, беременным и пожилым пациентам. Считается, что пребывание в стационаре необходимо в 50-70% случаев. Около 7% пациентов госпитализированы в отделения интенсивной терапии. Факт всасывания носителя должен вызывать тревогу в отношении смешанного заражения другими трансмиссивными клещевыми заболеваниями.Рекомендуется постельный режим до 3-5 дней при постоянной нормальной температуре тела. Лечение больных миокардитом проводится в строго горизонтальном положении. В связи с повреждением тканей печени назначается щадящая диета: исключаются маринады, жирные, жареные, кондитерские изделия, приправы, кофе, алкоголь. Питьевой режим должен быть увеличен из-за кипяченой воды и оральных растворов детоксикации.
Прогноз
Прогноз для своевременного выявления и лечения часто благоприятный, смертность составляет 3-5%. Симптомы сохраняются в течение нескольких недель, иногда месяцев. Важность человеческого моноцитарного эрлихиоза для современной клинической инфектологии заключается в потенциальном увеличении числа смертей от генерализованной формы заболевания среди растущего числа ВИЧ-инфицированных пациентов.
Профилактика
Специальной профилактики (вакцинации) нет. Неспецифические меры включают ношение рабочей одежды и закрытой обуви при посещении лесостепных территорий, использование средств против клещей, правильное удаление носителя при обнаружении и профилактическое назначение лечения этиотропными антибиотиками.
Список литературы
1. Анаплазмозы и эрлихиозы человека - новая проблема инфекционной патологии в России: пособие для врачей/ Рудаков Н. В., Шпынов С. Н., Оберт А. С. 2006.
2. Риккетсиозы человека (руководство для врачей)/ Лобан М., Лобзин Ю. В., Лукин Е. П. 2002.
3. вayesian Spatio-Temporal Analysis and Geospatial Risk Factors of Human Monocytic Ehrlichiosis/ Ram K. Raghavan, Daniel Neises, Douglas G. Goodin, Daniel A. Andresen,Roman R. Ganta// PLoS One - 2014 - №9.
4. Severe human monocytic ehrlichiosis presenting with altered mental status and seizures/ сhristian Geier, Jessica Davis, Marc Siegel//BMJ сase Rep. 2016 - №10.
2. Риккетсиозы человека (руководство для врачей)/ Лобан М., Лобзин Ю. В., Лукин Е. П. 2002.
3. вayesian Spatio-Temporal Analysis and Geospatial Risk Factors of Human Monocytic Ehrlichiosis/ Ram K. Raghavan, Daniel Neises, Douglas G. Goodin, Daniel A. Andresen,Roman R. Ganta// PLoS One - 2014 - №9.
4. Severe human monocytic ehrlichiosis presenting with altered mental status and seizures/ сhristian Geier, Jessica Davis, Marc Siegel//BMJ сase Rep. 2016 - №10.